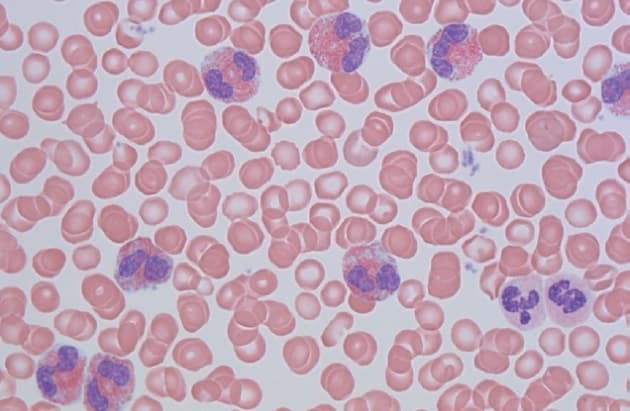
© Udstryg af perifert blod fra en patient med sekundær (reaktiv) eosinofili. (Foto: Michael Boe Møller).

Aktuelt
Patienter med eosinofili

© Udstryg af perifert blod fra en patient med sekundær (reaktiv) eosinofili. (Foto: Michael Boe Møller).
10. sep. 2018
1 min.
Patienter med eosinofili kan have en bred vifte af kliniske symptomer, som til tider kan være livstruende. Statusartiklen af Bjerrum et al beskriver de eosinofile granulocytters biologi, det kliniske spektrum, herunder de mest hyppige organmanifestationer, diagnostik samt behandling af den primære eosinofili.
Læs statusartiklen
Eosinofili
Ole Weis Bjerrum, Daniel El Fassi, Gitte Madsen et al